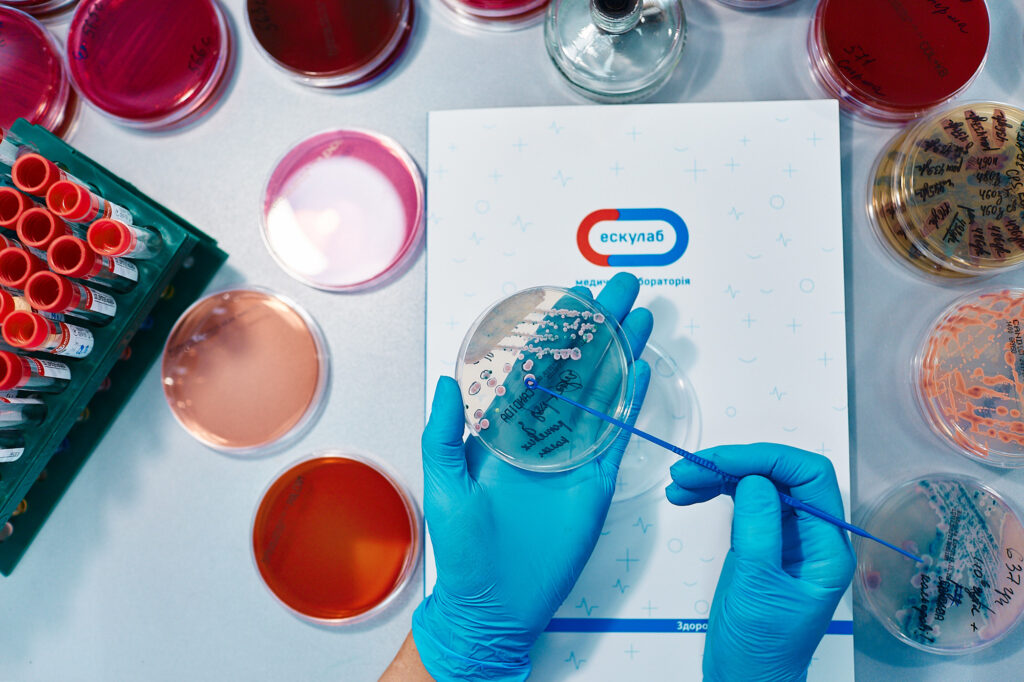
інтерв’ю Ескулаб вебпромо

«Заботься о себе сам!» Как Эскулаб разрушает стереотипы украинцев о здоровье и продвигает привычку профилактики заболеваний
Ведущая медицинская лаборатория Эскулаб имеет международный уровень качества диагностических исследований. Сеть представлена в 9 областях Украины и городе Киеве и насчитывает более 160 пунктов забора. С первых дней великой войны Эскулаб запустил бесплатные лабораторные исследования в рамках социальных инициатив, которыми уже воспользовались более 75 тыс. украинцев.
Анна Конык, СМО Эскулаб, в интервью Webpromo рассказала об инновационных подходах в работе медицинской лаборатории, разработке новой современной айдентики для бренда и благотворительных акциях, необходимых сегодня украинской аудитории. Искренний и откровенный разговор о сильной и дружеской команде, а также банальных и простых вещах, которые помогат двигаться вперед.

Анна Конык, СМО Эскулаб
Мы — команда: структура отдела маркетинга Эскулаб и отношения внутри коллектива
Как формировали команду маркетинга Эскулаб? На какие профессиональные и человеческие черты особенно обращаете внимание?
Я стала первым СМО Эскулаб. 5 лет назад, когда только пришла в компанию, не было нужды в должности. В настоящее время бренд быстро развивается.
Команду формировала постепенно и органично. Я брала людей на должности, где была большая потребность. Сначала собирала команду, опираясь на Hard Skills. Мне казалось, что Soft skills не столь важны. Когда первые несколько человек ушли, поняла, что что-то делаю не так. Теперь у меня другой подход. В первую очередь оцениваю, насколько человек вольется в команду, подходит ли он ментально к нашему коллективу. Должен быть коннект «хардов» и «софтов», но для этого нужно наработать опыт. Сейчас над маркетингом Эскулаба работает 11 сотрудников.
Как вы строите отношения в команде? Какой должна быть коммуникация внутри коллектива?
Всегда говорю, если вы что-то не поняли, придите и спросите. Возникают вопросы — говорите. Основное правило — это открытость. Я стараюсь быть максимально искренней к людям, потому что только в открытой атмосфере рождаются хорошие идеи и команда успешно реализует их.
Стараюсь хвалить сотрудников. Не всегда умею себя похвалить, потому работаю над этим. Важны также взаимоуважение, личные границы, которые должны быть обязательно в компании. Это фундамент, на котором строится дальнейшая коммуникация.
Какие новые должности появились в отделе маркетинга Эскулаба с начала вашего руководства?
Поскольку я формировала штат, все должности новые. Но отдел маркетинга построен по классической структуре — SMM, диджитал, дизайнеры, региональные руководители и менеджеры.
Как вы сегодня можете охарактеризовать свою команду? Полностью ли довольны тем, как построены рабочие процессы?
Я смело могу сказать, что мы — команда, которая искренне любит Эскулаб. Мы обожаем наших клиентов и по-хорошему «ненавидим» конкурентов. Всегда есть куда двигаться вперед и что улучшить.

Кто для вашей команды руководитель? Как вы себя позиционируете?
Команда часто называет меня маркетинг-мамой, так как всех их набирала я 🙂.
Хочу, чтобы сотрудники были самостоятельными и идейными. Но когда возникает необходимость в поддержке, помощи или совете, они могут прийти ко мне и мы совместно откорректируем вопросы.
О восстановлении рынка лабораторных услуг и специфике их продвижения
В каком состоянии сейчас находится рынок? Насколько изменилась ситуация и в какую сторону по сравнению с 2022 годом?
Рынок восстановился и растет. Открываются новые отделения как у Эскулаба, так и у конкурентов, что является хорошим показателем. 2022-й год — это был период выжить, сохранить команду.
Следует отметить, что до войны был COVID-19, который сработал как катализатор. Лабораторный рынок в это время развивался невероятно быстро. Каждый месяц мы открывали по десять отделений. Поэтому целесообразнее состояние сравнивать с «доковидным» периодом.
Сейчас ситуация выровнялась. 2023 год уже можно назвать годом небольшого роста. Вышли на довоенный период.
Насколько ниша актуальна в Украине именно сейчас? Наблюдаете ли изменение в настроениях украинцев, например, они стали больше заботиться о здоровье?
Безусловно, ниша актуальна. Тренд по поводу заботы о своем здоровье есть не только в Украине, но и во всем мире, и он растет. Это накладывается на лабораторный рынок тоже.
Я думаю, следующие поколения подхватят данную тенденцию и у них будет еще большая склонность к заботе о себе и своем здоровье. И это очень хорошо, потому что украинцы привыкли действовать по схеме, пока не заболело, никто к врачу не идет.
В чем специфика продвижения лабораторных услуг на рынке Украины? Какие главные сложности или проблемы существуют?
В сознании людей лабораторные анализы не самостоятельный продукт, а идут в комплексе с медициной. Это проблема, с которой нужно работать.
Наша задача — на простом и понятном языке рассказать клиентам, что означает каждый показатель. Они самостоятельно могут промониторить, какие показатели в норме и следует ли обратиться к врачу.

Какие существуют особенности регионального рынка? Назовите отличия по сравнению с международным?
За границей лабораторный рынок больше регулируется и финансируется государством. Частный медицинский рынок занимает небольшую долю и не развивается. К примеру, в Канаде вы без направления врача не можете сдать анализ.
У нас противоположная ситуация — в последние годы наблюдается тенденция сокращения доли государственного сектора, а частный медицинский лабораторный бизнес растет.
Какая ситуация была во время пандемии? Актуальна ли вообще сейчас услуга анализа на COVID-19?
Если коротко, то уже неактуальна. COVID-19 существует, но у населения совсем другое отношение к нему. Приблизительно знаем, как его лечить. Поэтому доля услуги в продажах минимальна.
Мы не думали, что может быть что-то хуже пандемии. Но сейчас для украинцев ковид не страшен.
Какие тенденции и тренды замечаете на рынке? Какие инновации или технологии возникают?
Главный — это тренд к профилактике, который я отмечала. Многие люди начали ежегодно делать чекап всего организма. Это классный здоровый тренд, которому мы особенно рады, потому что это наша безопасность. Медицинские центры часто говорят «мы заботимся о вас», Эскулаб говорит — «заботься о себе сам». Надо самостоятельно заботиться о своем здоровье.
В общем, лабораторный рынок стабилен, но всегда можно что-то улучшить. К примеру, сейчас в Эскулаб есть отбор биоматериала в VR очках. Особо услуга актуальна для детей. Во время процедуры они одевают очки и смотрят мультфильм. В Украине многие посещали государственные лабораторные центры, после которых остались неприятные ощущения и страхи перед сдачей медицинских анализов. Современные системы упрощают процесс и уменьшают уровень страха при отборе биоматериала.
В Европе и мире сейчас распространяется тренд по самоотбору. Существует определенный список таких анализов. К примеру, инфекции, которые передаются половым путем. Клиенту также приходит специальный бокс, который он затем упаковывает и отправляет. Я надеюсь, что этот тренд дойдет и до нас. Многие не хотят идти в лабораторию, стоять в очередях, общаться с медицинской сестрой. Некоторые стесняются озвучить конфиденциальную информацию. Это стресс для человека. Дома удобнее и легче все сделать.
Также бесконтактный отбор материала через специальные боксы. Это как почтомат, куда ты оставляешь свой отбор, и дальше ждешь результат.

«В онлайн много инвестиций не бывает»
Какую маркетинговую стратегию выбрали на текущий год? Как вы можете оценить ее эффективность?
Стратегию выбрали еще с начала войны, цель которой заключалась в заботе о здоровье украинского населения и страны в целом. Вообще, когда только началась полномасштабная война, было трудно начать коммуникацию, потому что ситуация была острой и был страх неправильно вступить.
Мы внедрили много социальных инициатив. Украинцам тяжело и здоровье, как правило, в этот момент «подводит». Потому запустили благотворительную акцию, где каждый мог сдать анализы за одну гривну. Почти бесплатно можно было проверить щитовидную железу, печень, гормоны. Таким образом, мы поддерживали постоянных клиентов Эскулаб, которые за неимением средств не имели возможности обследоваться, а также привлекали новую аудиторию, которая приходила по социальной инициативе.
Также это позволило украинцам прививать привычку беспокоиться о своем здоровье. А когда у человека возникает необходимость сдать анализы, он пойдет в лабораторию, в которой уже был. В результате у нас увеличилось количество клиентов и оборот компании.
Какие направления являются ключевыми для Эскулаба? Какие проекты стоят в приоритете?
Эскулаб — амбициозная компания. Через три года хотим стать лидером на рынке лабораторных услуг. Как отдел маркетинга стремимся быть №1 по приросту посетителей на сайте. Также хотим лучше «прирастать» в социальных сетях. Мы задаем идеи, тренды, которые подхватывают конкуренти.
В приоритете сейчас узнаваемость бренда и доверие к нему. В сфере медицины доверие очень важно. Когда возникла необходимость прийти в лабораторию, мне важно, чтобы клиент уже знал об Эскулабе. Для этого нужно превентивно с ним работать.
Как часто делаете анализ конкурентов? Кто из конкурентов ушел с рынка? Появились ли новые игроки?
Следим за конкурентами в социальных сетях, читаем новости каждый день о них. Дополнительно есть мониторинговые программы. Также проводим более глобальные исследования. Раз в год или когда возникает необходимость принять важное решение.
Могу сказать, что за период войны новых не появилось. Некоторые маленькие лаборатории закрылись, но мировые игроки рынка остались и работают.
В вашей нише преобладает онлайн или офлайн? Можете описать путь потребителя к приходу в лабораторию?
На сайте есть возможность заказать анализы. Но все равно нужно прийти в офлайн лабораторию. Постепенно растет количество заказов через сайт, особенно в больших городах. Сейчас доля онлайн достигает 30%.
Много инвестируем в SEO. Согласно данным SimilarWeb, в августе Эскулаб был вторым в рейтинге Google на рынке лабораторных услуг. Для сравнения еще год назад сайт занимал четвёртую позицию. При этом Эскулаб представлен только в девяти областях Украины и Киеве в отличие от конкурентов, имеющих большую географию. В онлайн слишком много инвестиций не бывает.
Планируете ли уже следующий «маркетинговый» год? Чем он будет отличаться от предыдущего?
Сейчас сотрудничаем с креативным агентством Bickerstaff.734 и разрабатываем новую айдентику бренда. Уже можно заметить, как изменились наши социальные сети. В течение следующего года будем постепенно внедрять изменения и в отделениях. В октябре запустили кампанию осведомленности о своем здоровье «Загляни вглубь себя», чтобы помочь украинцам лучше понимать себя.
Война в этом плане изменила нас. Если раньше план был минимум на год, то сейчас планируем на три месяца. Кроме того, на эти три месяца есть план «В» на случай, если не будет света или интернета. К сожалению, следует учитывать текущую ситуацию, поэтому с долгосрочного перешли на краткосрочное и суперкраткосрочное планирование.
Есть ли в планах выходить на международный рынок?
Нет пока. Как и отмечала, глобально ситуация с развитием лабораторного рынка отличается. На международном рынке он в основном регулируется государством.
Уместная, простая и понятная коммуникация Эскулаб
Как Эскулаб привлекает людей в коммуникацию? Назовите ключевые отличия от конкурентов?
Мы общаемся просто и понятно, отвечаем на вопросы. Наша информационная линия пытается понять боль клиента и максимально быстро помочь разрешить ситуацию.
Конечно есть процесс отбора материала, предполагающий стресс. Здесь важен качественный сервисный центр на отделениях. Поэтому много работаем над тем, чтобы отбор состоялся максимально комфортно и безболезненно, в приятной атмосфере. Стараемся нивелировать неприятное послевкусие после посещения. Все должно быть удобно, возле дома, быстро, без очередей.
Также заботимся об оперативной выдаче результатов.

Какая коммуникация считается уместной сегодня с учетом событий в Украине?
Уместно то, что полезно. Так было и до войны. Можем использовать ситуативный маркетинг, который круто «залетает». Но должен быть предел.
Как придумать оригинальную и креативную коммуникацию, которая «заденет» потенциального клиента?
Заденет коммуникация, которая отзывается. Для этого необходимо тестировать. Вообще суть маркетинга состоит в том, чтобы пробовать. Каждый раз это риск, потому что аудитория широкая. Но когда клиент видит коммуникацию и понимает, что это о нем, значит вы «попали в сердечко».
Как аудитория вообще реагирует на рекламу? Какой она должна быть сейчас в Украине?
Рынок восстановился, и уже можно не бояться.
Мы были одни из первых, кто запустил социальную рекламную кампанию в апреле 2022 года. В Эскулаб можно было бесплатно проверить группу крови и резус-фактор. Также запускали бесплатные курсы о предоставлении первой медицинской помощи в отделениях. Делали то, что было нужно. Соответственно, такую коммуникацию я не боялась запускать в рекламу.
Какую роль играет SMM? Как развиваете направление?
SMM очень важен. Сейчас вводим новую айдентику и для социальных сетей. Креативы, созданные искусственным интеллектом. Наша цель — найти то, за счет чего можем выделяться, потому что многие конкуренты копируют контент. Кроме этого любим экспериментировать, делать что-то новое.
Вообще у фармы реклама достаточно примитивна. Рекламы медицинских средств много и, часто, она прямая. Нам хочется зайти совсем с другой стороны, добавить юмора, сделать его более современным и трендовым. Хотим попасть в то же сердечко наших клиентов. Думаю, это будет крутой проект.

Сотрудничаете ли с инфлюенсерами? Если да, то насколько это сотрудничество было эффективным для Эскулаб? Почему выбрали именно такой подход?
Сотрудничаем и подходим к этому системно. Количество блогеров в Instagram или TikTok прописано в KPI отдела SMM. Специалист четко знает, сколько должно быть блогеров каждый месяц в каждой сети. Мы сотрудничаем с большим количеством блогеров, которые имеют разную аудиторию. Иногда модель сотрудничества с небольшими инфлюенсерами даже более эффективна, чем сотрудничество с миллионниками. Главное — это сотрудничество с оригинальными лидерами мнений.
Инфлюенс-маркетинг — мощный инструмент. Блогеров можно критиковать, но это работает. Рынок эффективно развивается и в ближайшие годы будет расти еще активнее. Но надо делать рекламу через инфлюенсеров максимально нативно, прямые продажи «в лоб» не работают. Для этого нужно правильно организовать работу блогера, объяснять и прилагать усилия. Порой бывает непросто, но это важно.
Благотворительные проекты и социальные инициативы во время войны
Какие благотворительные проекты или социальные инициативы запустили за последнее время или планируете?
Главная задача бизнеса и вообще украинцев — остановить агрессию и выбить всех москалей 🙂
В первые дни полномасштабной войны Эскулаб основал благотворительный фонд, в рамках которого запустили небольшое производство. Мы готовим сухие супы и завтраки. В меню есть «Файна зупка», «Файний борщик», а также «Файні сніданки».

Они удобные и быстро готовятся. За 1,5 года уже было передано около двух миллионов порций на фронт. Это очень важная миссия, ведь не всегда у военных есть возможность приготовить полноценный обед или ужин, а такая пища достаточно сытная и придает им силы и энергию. Как правило, зимой запросов на сухую пищу больше, поэтому сейчас активно готовимся.
Также запустили программу Check-UP за донат. На сайте или в лаборатории можно приобрести пакет из 4-х анализов за 1000 гривен. Все средства передаем в фонд.


Как правильно говорить с чувствительной аудиторией о теме благотворительности? Как привлекать людей к социальным проблемам, ведь с каждым разом все труднее привлечь их внимание?
Пробуем и учимся, потому что это действительно другая коммуникация.
Мы больше общаемся с бизнесом. Если условно необходимо сухое молоко, то обращаемся к поставщику и договариваемся. Так, Зерновита, Метро и Сильпо помогают закрывать потребность с крупами, львовские фермеры помогают овощами, а Белоцерковское снабжает сухим молоком. Мы друг друга поддерживаем.
Я очень горжусь украинским народом и бизнесом, который в такое тяжелое время не просто выживает и работает, но и помогает.
Как отдыхать, вдохновляться и радоваться банальным вещам
Присущ ли вам эмоциональный интеллект? Есть лайфхаки, как выходить из стрессовых ситуаций, при этом «не выпадать» из происходящих вокруг событий?
Я пока на пути к этому. Думаю, это скилл, который нужно постоянно развивать.
Вообще пытаюсь переключаться, ищу позитив, который отвлекает. Иногда бывает наоборот — надо погрузиться, посидеть, подумать, разложить по полочкам и понять, что все нормально, можно двигаться дальше. Зависит от ситуации или состояния, в котором я нахожусь.
Как отдыхаете? Что помогает «разгрузиться»?
Отдыхать нужно. Чтобы разгрузиться мне нужны новые эмоции. Я люблю пробовать что-нибудь новое, посещать новые места. Это могут быть классные локации в Карпатах или новое заведение во Львове. Люблю путешествовать.

Маркетолог всегда ищет вдохновение. Я посещаю отделения Эскулаб или конкурентов. В такие моменты появляются новые идеи, которые могу имплементировать в работу.
Что вас вдохновляет?
Вдохновляют наши достижения. Но в такое непростое время действительно нужно радоваться каждый день простым банальным вещам. К примеру, мы с вами сейчас пообщались и получили положительные эмоции — это классно. Вкусный кофе с утра — вообще супер 🙂.
Если сейчас я дома и имею возможность обнять родных и близких людей, то это невероятное счастье.







